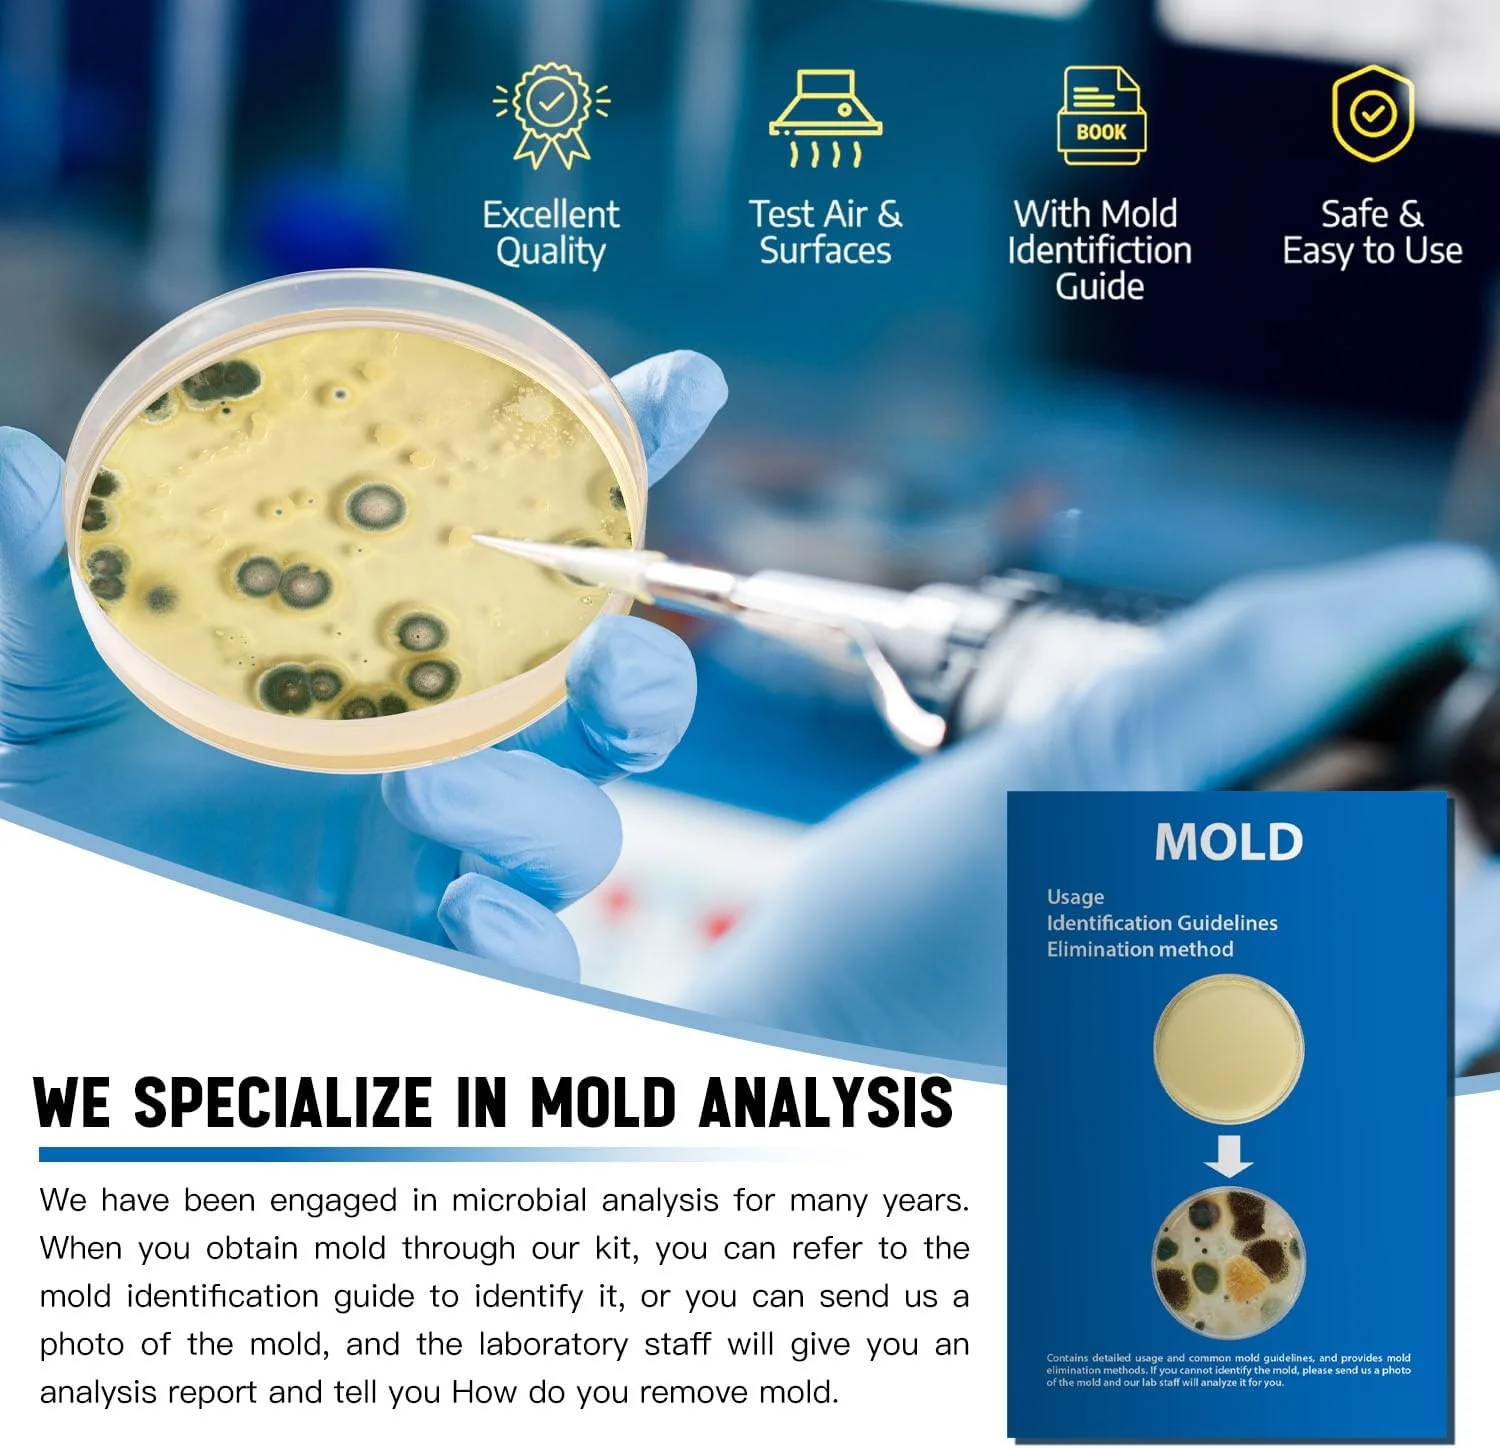
کیت تست کپک برای خانه - کیت تست کپک DIY با 12 تست جداگانه - آشکارساز کپک سیاه - تست کننده کیفیت هوای داخل ساختمان - راهنمای شناسایی کپک - تجزیه و تحلیل آزمایشگاهی رایگان - آشکارساز کپک سریع و قابل اعتماد در خانه

اشتراک گذاری

کیت تست کپک برای خانه - کیت تست کپک DIY با 12 تست جداگانه - آشکارساز کپک سیاه - تست کننده کیفیت هوای داخل ساختمان - راهنمای شناسایی کپک - تجزیه و تحلیل آزمایشگاهی رایگان - آشکارساز کپک سریع و قابل اعتماد در خانه
- برند :سایر برند ها

ارسال تا 7 روز کاری(پس از دریافت در کشور مبدا)

اصالت کالا(100% ارجینال)

پشتیبانی 24 ساعته(7 روز هفته به صورت 24 ساعته)
در حال بروزرسانی قیمت
کیت تست کامل: 12 پلیت تست، به شما این امکان را می دهد که ارزیابی های کامل و گسترده کپک را در سرتاسر خانه خود انجام دهید، سواب ها، کیسه مهر و موم شده، برگه های برچسب و دستکش های تست، راهنمای شناسایی کپک با جزئیات، کیت ما شامل هر چیزی است که شما نیاز دارید.
 واتساپ
واتساپ